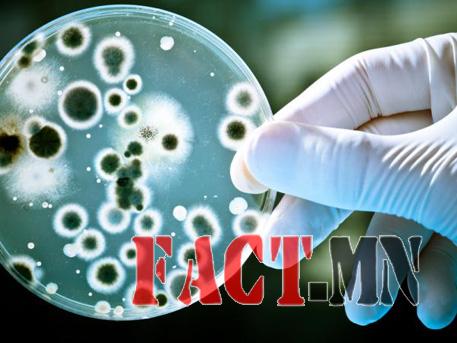

2050 он гэхэд эмэнд тэсвэртэй халдварын улмаас жилд 10 сая хүн нас барна
2050 он гэхэд “Super bug” буюу ямар ч эмэнд дийлддэггүй, эмэнд тэсвэртэй нян гурван секунд тутамд нэг хүний аминд хүрнэ гэсэн судалгааг Их Британийн “Review on Antimicrobial Resistance” гэдэг судалгааны байгууллага гаргажээ. Хүн төрөлхтөнийг энэхүү нянгаас хамгаалах эмчилгээний төлөвлөгөөг энэ судалгааны үндсэн дээр боловсруулан гаргахад олон тэрбум ам.долларын хөрөнгө оруулалт шаардлагатай аж. Антибиотикт дарагддаггүй халдварт өвчний вирустэй тэмцэх нь дэлхийн хэмжээнд тулгамдсан асуудлуудын нэг бөгөөд энэ нь терроризмтой зүйрлэхүйц том аюул юм.
2050 он гэхэд “Super bug” буюу ямар ч эмэнд дийлддэггүй, эмэнд тэсвэртэй нян гурван секунд тутамд нэг хүний аминд хүрнэ гэсэн судалгааг Их Британийн “Review on Antimicrobial Resistance” гэдэг судалгааны байгууллага гаргажээ. Хүн төрөлхтөнийг энэхүү нянгаас хамгаалах эмчилгээний төлөвлөгөөг энэ судалгааны үндсэн дээр боловсруулан гаргахад олон тэрбум ам.долларын хөрөнгө оруулалт шаардлагатай аж. Антибиотикт дарагддаггүй халдварт өвчний вирустэй тэмцэх нь дэлхийн хэмжээнд тулгамдсан асуудлуудын нэг бөгөөд энэ нь терроризмтой зүйрлэхүйц том аюул юм.Дэлхий дээр хангалттай хэмжээгээр шинэ антибиотик үйлдвэрлэдэггүй бөгөөд байгаа антибиотикийг замбараагүй хэрэглэдэг.
Их Британийн судалгааны байгууллага 2014 оноос хойш эмэнд тэсвэртэй халдварын талаарх судалгаа хийж байгаа бөгөөд өнгөрсөн хугацаанд нэг сая гаруй хүн ийм халдварын улмаас нас барсан байна. Түүнчлэн эмч нар 1950-иад оны үед гарган авсан “колистин” хэмээх антибиотик эсэргүүцэх чадвартай нян байдгийг илрүүлсэн нь дэлхий дахин антибиотикийн дараах эрин үед шилжин орох хэрэгтэйг харуулж байна хэмээн шинжээчид үзэж байна. Нөхцөл байдал 2050 онд гэхэд улам бүр дордсоноор эмэнд тэсвэртэй халдварт өвчний удмаас жил бүр 10 сая хүн нас барах болно гэж судалгаанд дурдсан байна.
URL:













